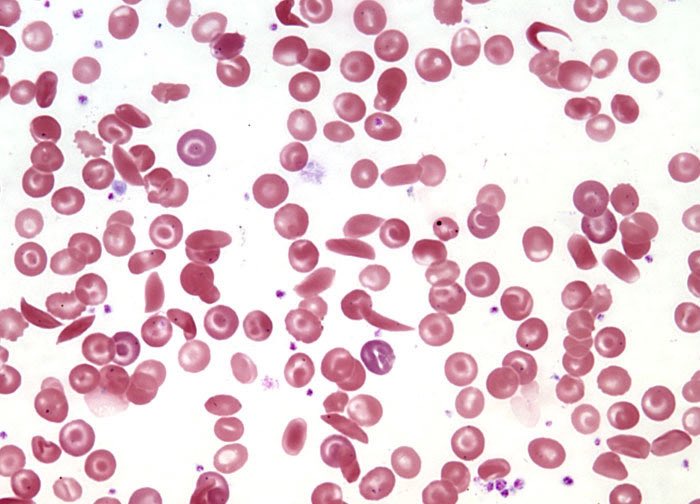
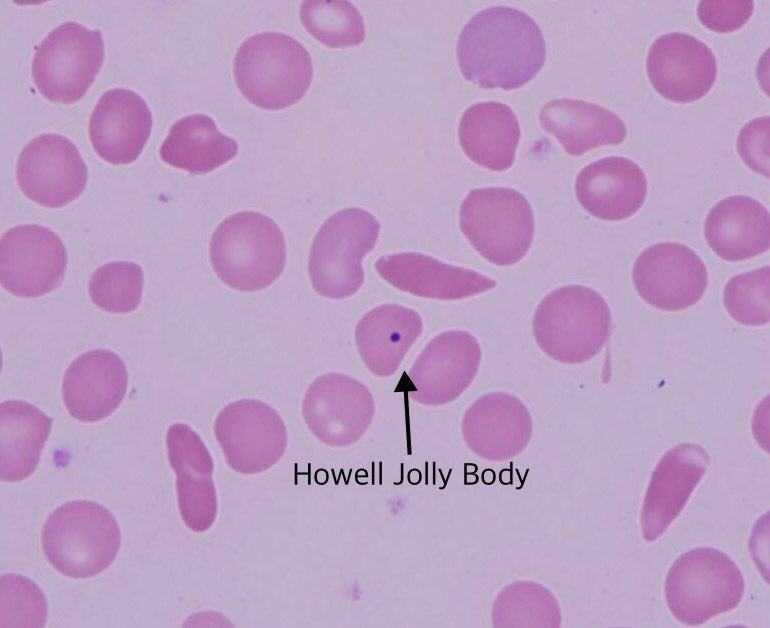

Sickle cell Disease ✨
باختصار هو مرض وراثي من أنواع hemolytic anemia ناتج من حدوث mutationفي الامينو أسيد في Beta chain في position 6 يحدث استبدال للحمض الأميني بحيث يوجد valine بدلا من glutamic acid
#يوميات_اخصائي_مختبر #مختبرات_طبية
باختصار هو مرض وراثي من أنواع hemolytic anemia ناتج من حدوث mutationفي الامينو أسيد في Beta chain في position 6 يحدث استبدال للحمض الأميني بحيث يوجد valine بدلا من glutamic acid
#يوميات_اخصائي_مختبر #مختبرات_طبية
تغير شكل RBC ل شكل Sickle حيسبب بعض المشاكل:
تعالو نشرحها باختصار👌✨
١- عدم قدرة RBCعلى حمل O2 بفعالية وهذا يرجع لتغير شكل الخلايا
٢- فقدان ال flexibility في الوصول للشعيرات الدقيقة
٣-شكلها الجديد له القدرة على التصاق الخلايا ببعضها ف يزيد احتمالية حدوث الجلطات
تعالو نشرحها باختصار👌✨
١- عدم قدرة RBCعلى حمل O2 بفعالية وهذا يرجع لتغير شكل الخلايا
٢- فقدان ال flexibility في الوصول للشعيرات الدقيقة
٣-شكلها الجديد له القدرة على التصاق الخلايا ببعضها ف يزيد احتمالية حدوث الجلطات
٤- الخلية اللي تاخد شكل Sickle يكون Half life تبعها من ١٠-٢٠ يوم بدلًا من ٩٠-١٢٠ يوم لخليةRBC الطبيعية
٥- خلاياRBC تتكسر في اماكن محددة لكن الSickle cell تتكسر داخل للشعيرات الدموية ويحدث ما يسمى Intra-vascular hemolysis ف يكون عندنا Free Hb داخل الأوعية هذا الHb له القدرة على سحب Nitric Oxide اللي دورها هو توسيع الأوعية الدموية ف يحدث هنا ضيق للأوعية الدموية
٦- بما ان عمر الخلية قل الجسم يحاول يصنع RBC بشكل سريع عشان يعوض النقص الحاصل من الbone marrow فيحدث عندنا ما يسمى Bone Marrow Hyperplasia
كمان الجسم يحاول يصنعRBC من اماكن أخرى غير نخاع العظم زي الكبد مثلا ف يحدث تضخم للكبد نسمي Hepatomegaly
كمان الجسم يحاول يصنعRBC من اماكن أخرى غير نخاع العظم زي الكبد مثلا ف يحدث تضخم للكبد نسمي Hepatomegaly
طيب متى نقول الشخص دا مصاب ب Sickle ؟ لازم يكون عنده جين من احد الأبوين ولا لازم الاثنين ؟
حنقول عشان نقول دا شخص عندو
Sickle cell disease لازم يكون أخذ الجين المصاب من الأب والجين المصاب من الأم يعني عندو جينين حدث فيها ال mutation
حنقول عشان نقول دا شخص عندو
Sickle cell disease لازم يكون أخذ الجين المصاب من الأب والجين المصاب من الأم يعني عندو جينين حدث فيها ال mutation
٢- Episodes of pain
آلام شديدة او نسميها نوبة الألم ؛ قلنا شكل Sickleيجعل عندها قابلية للالتصاق وبكذا تتجمع وتقفل الوعاء الدموي لأي عضو نسميها
Vaso-Occlusive ف الأنسجة تعاني من نقص الأكسجين ويتشكل في الم وممكن يسبب تلف للأنسجة
آلام شديدة او نسميها نوبة الألم ؛ قلنا شكل Sickleيجعل عندها قابلية للالتصاق وبكذا تتجمع وتقفل الوعاء الدموي لأي عضو نسميها
Vaso-Occlusive ف الأنسجة تعاني من نقص الأكسجين ويتشكل في الم وممكن يسبب تلف للأنسجة
غالبا تكون الأم في المفاصل " اليد والقدم" دا اكثر شي يكون عند الأطفال و ممكن في البطن - العظام- القلب - الصدر
٣- Frequent infection
عدوى متكررة بسبب انو الspleen مع الوقت تقل كمية الدم الواصلة له لان ذكرنا خلايا sickle تتجمع وتقفل الوعاء الدموي ف حجم الspleenيصغر وما يعمل بفعاليه يعني باختصار نقول يحدث "تليف"نسميه Autospleenectomy
عدوى متكررة بسبب انو الspleen مع الوقت تقل كمية الدم الواصلة له لان ذكرنا خلايا sickle تتجمع وتقفل الوعاء الدموي ف حجم الspleenيصغر وما يعمل بفعاليه يعني باختصار نقول يحدث "تليف"نسميه Autospleenectomy
طبعا وظيفة الspleenانو يتخلص من بعض أنواع البكتيريا زي :
Salmonell
Neisseria
H.influenzae
Strep Pneumonia
وفي دي الحاله الجسم ما يقدر يقاومها او يتغلب عليها
٤-Delayed growth
وقلنا بسبب قلة كمية الأكسجين الواصل للأنسجة
٥- vision problem
٦-Painful swelling of hands and feet
Salmonell
Neisseria
H.influenzae
Strep Pneumonia
وفي دي الحاله الجسم ما يقدر يقاومها او يتغلب عليها
٤-Delayed growth
وقلنا بسبب قلة كمية الأكسجين الواصل للأنسجة
٥- vision problem
٦-Painful swelling of hands and feet
دي معلوماتنا اليوم ويارب تكون سهلة وبسيطة عليكم وتنال استحسانكم 🌸✨
لاتنسوني من دعواتكم 🙏
لاتنسوني من دعواتكم 🙏
Loading suggestions...